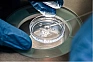

|
|
|
|
|
| Pusat Kesihatan Reproduktif "SM-Clinic" | 4.85 | Dari konsultasi pertama hingga kelahiran anak | |
| 1 | REMEDI. Institut Perubatan Reproduktif | 4.53 | Nisbah optimum harga dan kualiti perkhidmatan |
| 2 | Untuk kelahiran | 4.52 | Kecekapan tinggi program IVF |
| 3 | Sebelum | 4.48 | Pengarangan yang produktif |
| 4 | ibu | 4.43 | Kos perundingan terbaik |
| 5 | Pusat Perubatan Pelbagai Bidang Klinik IVF Akademik Moscow (MAC IVF) | 4.40 | Keadaan yang menggalakkan untuk penduduk Moscow dan kawasan lain |
| 6 | K+31 Petrovsky Gates | 4.40 | Bilangan maksimum bidang kerja |
| 7 | VitroClinic | 4.33 | Risiko minima kehamilan berganda |
| 8 | Klinik Profesor Zdanovsky | 4.31 | Klinik yang paling dipercayai |
| 9 | Klinik Nova | 4.29 | Peralatan yang inovatif |
| 10 | bayi tabung uji | 4.22 | Rangkaian penuh perkhidmatan IVF untuk CHI |
| 11 | Pusat Saintifik Obstetrik, Ginekologi dan Perinatologi dinamakan sempena Ahli Akademik V. I. Kulakov | 4.09 | Klinik paling popular |
| 12 | AltraVita | 4.02 | Perundingan dalam talian dan di rumah |
| 13 | Mira | 3.95 | Teknologi Pembiakan Berbantu |
| 14 | Pusat Perubatan Eropah (EMC) | 3.89 | Jadual kerja 24 jam |
| 15 | Pusat Perancang Keluarga dan Pembiakan | 3.81 | Diagnostik genetik berketepatan tinggi |
Malangnya, ramai pasangan menghadapi masalah mengandung anak. Selalunya ia berlaku kerana ketidaksuburan salah seorang pasangan. Penyakit ini boleh menjadi mutlak (iaitu, disebabkan oleh kecacatan perkembangan, perubahan yang tidak dapat dielakkan dalam alat kelamin, dll.) dan relatif (mampu disembuhkan). Baru-baru ini, saintis telah menemui cara untuk memerangi ketidaksuburan mutlak. Prosedur IVF (persenyawaan in vitro) membolehkan pasangan yang didiagnosis dengan ketidaksuburan untuk melahirkan bayi yang sihat. Tujuannya adalah untuk memastikan persenyawaan dan, dalam beberapa kes, pemeliharaan embrio dengan cara tertentu, diikuti dengan penanaman semula. Pasangan moden boleh beralih ke klinik khas, yang pakarnya menjalankan prosedur IVF. Pilihan pusat perubatan adalah perkara yang sangat penting, di mana keputusannya bergantung kepada sebahagian besarnya. Untuk tidak membuat kesilapan dengan klinik, kami menasihati anda untuk memberi perhatian kepada:
- Ketersediaan lesen. Titik wajib - baca dengan teliti dokumen pusat perubatan.
- Pelbagai perkhidmatan. Kehadiran makmal sendiri membolehkan pusat itu menyediakan pesakitnya dengan pelbagai kajian di satu tempat. Dan kehadiran pakar sempit (mammologi, ahli terapi, dll.) Akan menjimatkan masa untuk pergi ke institusi lain.
- Bilangan pendaratan yang berjaya. Statistik positif akan memberitahu tentang kualiti klinik.
- Profesionalisme pekerja. Doktor mesti pakar yang berpengalaman, kerana pada mereka keputusan prosedur bergantung terutamanya. Klinik harus mempunyai pakar reproduksi dan embriologi yang baik mengenai kakitangan.
- Syarat tinggal di klinik. Semasa penyediaan untuk prosedur sedemikian, keadaan yang selesa dan steril perlu dicipta.
Klinik yang paling dipercayai di Moscow termasuk dalam penarafan kami. Mereka 100% memenuhi kriteria yang dibentangkan di atas. Harga di pusat perubatan untuk IVF bermula dari 100,000 rubel. Semua klinik bekerja dengan kuota negeri, memberikan diskaun dan mengadakan promosi.
15 teratas. Pusat Perancang Keluarga dan Pembiakan
Di makmal PGD kami sendiri, lebih daripada 40 penyakit monogenik dan masalah kromosom dengan diagnosis ketepatan tinggi sedang dikaji.
- Alamat: Moscow, Sevastopolsky pr-t, 24a
- Waktu buka: Isnin-Jumaat. dari jam 8:00 hingga 20:00; Sab. dari 9:00 hingga 14:00; Matahari. dari jam 10:00 hingga 14:00
- laman web: cps-moscow.ru
- Perundingan utama pakar: dari 2500 rubel.
- Program IVF: dari 100,000 rubel.
- Inseminasi buatan: 18,000 rubel.
- Pada peta
Dalam kompleks pelbagai struktur, rawatan kemandulan dan jabatan IVF adalah salah satu yang terbaik dari segi keputusan. Bilangan percubaan inseminasi buatan yang berjaya adalah 35-40%. Lebih 150 pesakit sedang dirawat pada masa yang sama. Oleh itu, barisan besar tidak terkumpul di sini, ada temu janji awal. Senarai perkhidmatan termasuk semua program IVF yang digunakan dalam perubatan moden. Prosedur OMS tersedia. Kehadiran makmal yang serba lengkap membolehkan anda memilih untuk bayi walaupun jenis darah dan faktor Rh. Pesakit perhatikan perhatian, keramahan ramai doktor, yang menerangkan secara terperinci pelan tindakan dan pelantikan. Klinik ini mempunyai 2 masalah serius yang menyebabkan pesakit menurunkan rating mereka.Ini termasuk kekasaran jururawat dan ketidaktepatan mereka ketika memberikan ubat, serta ketidakpatuhan doktor terhadap masa merekod pesakit.
- Makmal PGD moden
- IVF boleh didapati di bawah insurans perubatan wajib
- Kecekapan dan keramahan doktor
- Harga sederhana
- Bukan selalu jangka panjang
- Doktor kadang-kadang lewat untuk temujanji
- Kakitangan yang tidak jujur dan kasar
14 teratas. Pusat Perubatan Eropah (EMC)
Adalah sangat penting bagi pesakit bahawa mereka boleh sentiasa berhubung dengan doktor mereka, tepat pada masanya untuk menyelesaikan masalah dalam situasi kecemasan.
- Alamat: Moscow, st. Shchepkina, 35
- Waktu buka: sepanjang masa
- Tapak: emcmos.ru
- Perundingan utama pakar: dari 4190 rubel.
- Program IVF: dari 165278 rubel.
- Inseminasi buatan: pengiraan individu
- Pada peta
Rawatan yang disediakan dijalankan mengikut kaedah yang paling moden. Makmal pusat memenuhi keperluan piawaian antarabangsa. Di sini mereka melakukan pelbagai kajian, mengambil sebarang ujian dan hanya menggunakan bahan habis yang berkualiti tinggi. Selain itu, peralatan teknikal canggih EMC membolehkan anda mendapatkan hasil yang terbaik. Lebih daripada 3,000 pasangan telah menjadi ibu bapa yang bahagia berkat kerja pakar klinik. Pusat ini mempunyai bank krio sendiri. Pengalaman selama 29 tahun membolehkan kami memberikan bantuan berkelayakan tinggi kepada wanita yang didiagnosis dengan ketidaksuburan. Ia menggaji pasukan profesional dari negara berbeza yang berpengalaman dalam klinik terkemuka dunia. Ciri penting ialah pusat beroperasi sepanjang masa.
- Diagnosis yang tepat
- Teknik moden
- Makmal memenuhi piawaian
- Bekerja sepanjang masa
- Tak boleh call selalu
- Terlalu mahal
- Tempat letak kereta berbayar
13 teratas. Mira
Klinik menyediakan madu. Perkhidmatan ART, pakar pusat membantu pasangan menjadi ibu bapa dengan campur tangan yang minimum.
- Alamat: Moscow, st. Ahli akademik Zelinsky, 38, cor. lapan
- Waktu buka: setiap hari dari 8:00 hingga 20:00
- laman web: clinica-mira.ru
- Perundingan utama pakar: dari 3000 rubel.
- Program IVF: pengiraan individu
- Inseminasi buatan: 38,000 rubel.
- Pada peta
Sebuah institusi perubatan pelbagai disiplin di Moscow menyediakan rangkaian penuh perkhidmatan untuk persenyawaan in vitro. Semuanya bermula dengan pemeriksaan pasangan suami isteri, termasuk doktor kepakaran berkaitan. Senarai ujian makmal termasuk spermogram dan ujian MAP. Diagnostik embrio yang paling berkesan dilakukan. Jika perlu, inseminasi intrauterin, ICSI, PICSI dilakukan. Penetasan berbantu digunakan untuk mengamankan perlekatan embrio. Kami mempunyai bank cryo kami sendiri, di mana biomaterial disimpan selama beberapa tahun. Pengunjung menganggap keengganan sesetengah doktor untuk menerangkan secara terperinci temu janji dan keputusan ujian sebagai kelemahan.
- Pelbagai perkhidmatan
- Pemeriksaan pelbagai peringkat pesakit
- Senarai besar ujian makmal
- Bank krio biomaterial sendiri
- Pesakit tidak selalu memberi komen tentang keputusan ujian
- Kakitangan biadap di kaunter penerimaan tetamu dan daftar keluar
- Terdapat salah faham kerana rakaman yang salah
Lihat juga:
12 teratas. AltraVita
Pakar reproduktif, pakar embriologi, pakar sakit puan dan andrologi membantu pesakit dalam talian dan di rumah.
- Alamat: Moscow, st. Nagornaya, 4a
- Waktu buka: setiap hari dari 8:00 hingga 20:00
- laman web: altravita-ivf.ru
- Perundingan utama pakar: dari 2650 rubel.
- Program IVF: 230,900 rubel.
- Inseminasi buatan: 35700 rubel.
- Pada peta
Doktor yang berpengalaman dengan cepat dan cekap menjalankan pemeriksaan lengkap untuk menubuhkan diagnosis yang tepat dan mencari cara untuk menyelesaikan masalah. Bagi wanita, keselesaan lengkap disediakan sebelum dan semasa prosedur. Dianggarkan lebih 13,000 kehamilan berlaku sepanjang 15 tahun institusi itu beroperasi. Ia mempunyai makmal sendiri dan peralatan terkini. Klinik ini kerap memperkenalkan teknologi baharu dan menguasai teknik inovatif. Pada tahun 2016, AltraVita menerima sijil emas CAP. Klinik ini sering mengadakan hari terbuka dengan penerimaan percuma pakar reproduktif, serta madu. Pusat ini menyediakan diskaun untuk perundingan dengan pakar. Klinik itu, walaupun mendapat penarafan yang terbaik, masih mempunyai beberapa kelemahan. Ini termasuk kesilapan dalam diagnosis, beratur panjang dan mengenakan perkhidmatan.
- Semakan kualiti yang lengkap
- Pengenalpastian masalah pantas
- Makmal sendiri
- Kompleks program IVF
- Banyak feedback positif
- Harga tinggi
11 teratas. Pusat Saintifik Obstetrik, Ginekologi dan Perinatologi dinamakan sempena Ahli Akademik V. I. Kulakov
Organisasi perubatan mendapat paling banyak ulasan dalam penarafan.
- Alamat: Moscow, st. Ahli akademik Oparina, 4
- Waktu buka: Isnin-Jumaat. dari jam 8:00 hingga 19:00; Sab. dari 9:30 hingga 14:00
- Tapak: ncagp.ru
- Perundingan utama pakar: dari 2500 rubel.
- Program IVF: pengiraan individu
- Inseminasi buatan: pengiraan individu
- Pada peta
Pusat Saintifik. DALAM DAN. Kulakova ialah klinik IVF tertua di Rusia dan salah satu peneraju utama dalam ranking. Bayi tabung uji pertama telah dikandung di sini pada tahun 1985. Sejak itu, lebih daripada 18 ribu kanak-kanak telah dilahirkan. Pusat ini dianggap yang terbesar di negara ini dan mempunyai lebih 53 unit dan 17 makmal klinikal. Malah ahli akademik Akademi Sains Perubatan Rusia bekerja di klinik. Pesakit dengan kuota insurans perubatan wajib sering datang ke sini. Di sini anda boleh lulus semua ujian yang diperlukan dan menjalani peperiksaan lengkap. Jika anda mempunyai sebarang pertanyaan, anda boleh menghubungi pusat maklumat dengan menghubungi talian hotline. Klinik ini mempunyai kadar kejayaan yang tinggi dalam rawatan kemandulan dan prosedur IVF. Ketidakpuasan hati dinyatakan oleh sesetengah pesakit, yang menurutnya doktor secara berkala membuat temu janji tambahan untuk ujian. Selain itu, tidak semua orang menyukai sikap sesetengah doktor terhadap pesakit.
- Pakar Berpengalaman
- Rangkaian struktur cawangan dan makmal yang luas
- Talian hotline yang berfungsi dengan baik
- Program IVF tersedia untuk insurans perubatan wajib
- Terdapat kes ujian yang tidak perlu
- Terdapat aduan mengenai pengurusan kehamilan
- Doktor tidak selalu menjaga ibu bapa masa depan
10 teratas. bayi tabung uji
Anda boleh menjalani semua prosedur yang diperlukan di bawah insurans perubatan wajib, daripada rangsangan ovulasi hingga pemindahan embrio ke dalam rongga rahim.
- Alamat: Moscow, st. Schukinskaya, 2
- Waktu buka: Isnin-Jumaat. dari jam 8:00 hingga 20:00; Sab. dari 9:00 hingga 17:00
- laman web: baby-ivf.ru
- Perundingan utama pakar: dari 4100 rubel.
- Program IVF: dari 113,000 rubel.
- Inseminasi buatan: pengiraan individu
- Pada peta
Institusi perubatan merawat pelbagai jenis kemandulan, melaksanakan teknologi IVF moden, keberkesanannya secara purata 30%. Selain itu, perkhidmatan ICSI, IMSI, PIKSI disediakan. Ia adalah mungkin untuk menggunakan biomaterial penderma daripada cryobank. Apabila melaksanakan program ibu tumpang, sokongan penuh undang-undang disediakan. Setiap arah IVF ditawarkan dengan mengambil kira ciri-ciri individu, keputusan peperiksaan. Dalam ulasan, pesakit mengucapkan terima kasih kepada doktor atas perhatian mereka, empati, rawatan lembut, dan ketiadaan rujukan untuk ujian yang tidak bermaklumat. Bagaimanapun, semua peperiksaan di bawah kuota negeri dibayar di sini, dan agak mahal. Terdapat juga aduan tentang diagnosis yang salah dalam kes yang sukar.
- Rawatan kemandulan yang berkesan
- Perkhidmatan tambahan disediakan dalam program IVF
- Surrogacy
- Tiada rujukan yang tidak perlu untuk ujian dan peperiksaan lain
- Tidak selalu kerja pentadbir yang berkualiti tinggi
- Ujian tambahan yang mahal walaupun dengan kuota
- Terdapat pakar yang salah mendiagnosis
9 teratas. Klinik Nova
Klinik ini dilengkapi dengan sistem paling moden syarikat terkemuka di semua peringkat, termasuk bilik operasi dan makmalnya sendiri.
- Alamat: Moscow, st. Lobachevsky, 20
- Waktu buka: Isnin-Jumaat. dari 9:00 hingga 20:00; Sabtu-Ahad dari 9:00 hingga 18:00
- Tapak: nova-clinic.ru
- Perundingan utama pakar: dari 4500 rubel.
- Program IVF: dari 111,000 rubel.
- Inseminasi buatan: dari 18,000 rubel.
- Pada peta
Ia dianggap sebagai salah satu yang terbaik di Moscow terima kasih kepada profesional kelas atas, sikap prihatin dan, yang paling penting, keputusan cemerlang. Pesakit kumpulan kompleks (bentuk idiopatik, umur pembiakan yang lebih tua) diterima di sini. Prestasi tinggi dicapai melalui penggunaan peralatan berteknologi tinggi dan bahan guna habis yang diperakui. Di sinilah anda boleh memohon untuk menerima perkhidmatan CHI. Skim individu dipilih untuk setiap pesakit. Sebelum prosedur, kedua-dua pasangan lulus pelbagai ujian. Mereka juga mendedahkan kemungkinan patologi pada anak yang belum lahir. By the way, selepas mengandung, klinik menyediakan perkhidmatan penjagaan kehamilan. Benar, pemerhatian di sini agak mahal - 185,100 rubel. untuk semua trimester. Juga, pesakit tidak suka keperluan untuk menunggu temujanji, kekurangan ubat (anda perlu membelinya sendiri).
- Kadar kejayaan IVF 53%
- Pengurusan pesakit yang sangat sukar
- Terdapat perkhidmatan IVF untuk insurans perubatan wajib
- Pengurusan kehamilan
- Lama menunggu walaupun dengan janji temu
- Pengurusan kehamilan yang mahal
- Ubat yang anda perlukan tidak selalu tersedia.
8 teratas. Klinik Profesor Zdanovsky
Salah satu syarikat tertua di Moscow disesuaikan sepenuhnya untuk pesakit yang mempunyai kedua-dua kes penyakit biasa dan jarang berlaku, terutamanya yang teruk.
- Alamat: Moscow, lorong Kholodilny, 2, bangunan 2
- Waktu buka: Isnin-Jumaat. dari jam 8:00 hingga 20:00; Sabtu-Ahad dari 9:00 hingga 15:30
- laman web: budutdeti.ru
- Perundingan utama pakar: dari 3000 rubel.
- Program IVF: dari 141,000 rubel.
- Inseminasi buatan: 25,000 rubel.
- Pada peta
Klinik yang tinggal lama dalam pasaran khusus telah mengumpul pengalaman luas dalam bekerja dengan pelbagai jenis ketidaksuburan, IVF. Peserta penarafan popular kerana diagnosis tepat masalah, ujian makmal dalam masa yang singkat. Antara perkhidmatan tersebut ialah konsultasi dan rawatan oleh pakar sakit puan, pakar urologi, pakar onkologi, pakar embriologi. Sebagai tambahan kepada teknologi utama, ICSI, TESA / PESA, inseminasi intrauterin digunakan. Sel kuman penderma dan embrio memperluaskan peluang untuk beberapa pasangan dan wanita bujang. Ia menawarkan pesakit pengganti ibu, yang ditunjukkan untuk mereka yang tidak boleh hamil atas sebab perubatan yang serius. Antara kelemahan, pesakit klinik mencatatkan kesejukan dan keangkuhan di pihak beberapa pakar, serta tidak selalu berjaya menyelesaikan protokol.
- Kehadiran jangka panjang di pasaran Moscow
- Diagnosis dan rawatan kemandulan yang tepat
- Pangkalan makmal yang kuat
- Program tambahan, termasuk penderma
- Rujukan penyelidikan tidak mencukupi
- Doktor Sombong Bertemu
Lihat juga:
7 teratas. VitroClinic
Klinik ini menggunakan pakar embriologi genetik berpengalaman berdasarkan teknologi terkini dan peralatan paling moden, yang memastikan hasil jangkaan berkualiti tinggi.
- Alamat: Moscow, Volokolamsky proezd, 1a
- Waktu buka: Isnin-Jumaat. dari 8:00 hingga 20:00
- Tapak: vitroclinic.ru
- Perundingan utama pakar: dari 4500 rubel.
- Program IVF: dari 160,000 rubel.
- Inseminasi buatan: dari 30,000 rubel.
- Pada peta
Klinik itu, yang dianugerahkan anugerah "Crystal Vial", terkenal dengan pendekatan komprehensifnya dalam mencapai matlamat utama - kehamilan, selepas itu pesakit diambil sehingga bersalin. Pada peringkat awal, jika perlu, pasangan itu akan dirujuk mengenai isu ketidaksuburan wanita dan lelaki oleh pakar reproduksi, andrologi, embriologi. Program IVF dengan rangsangan minimum dipilih, termasuk pilihan penderma. Sekiranya terdapat tanda-tanda, ICSI dilakukan, yang memberikan kecekapan yang lebih tinggi. Kaedah PICSI tambahan memastikan pemilihan spermatozoa yang teliti. Pada sisi negatifnya, pelawat mempunyai barisan panjang dan komunikasi yang singkat dengan doktor. Institusi perubatan bekerja setiap hari (kecuali hujung minggu), adalah mungkin untuk menerima perundingan melalui telefon. Klinik ini tidak mempunyai pendekatan peribadi, yang beberapa pesakit mengadu. Kerana ini, kegagalan berlaku semasa pemindahan embrio, inseminasi buatan.
- Pendekatan yang kompleks
- Perundingan Kemandulan
- Satu set program yang berkesan
- Pangkalan data bahan penderma yang luas
- Beratur panjang untuk doktor
- Temu janji singkat
- Secara berkala terdapat kegagalan kerana kesilapan doktor
Lihat juga:
6 teratas. K+31 Petrovsky Gates
Klinik ini berfungsi serta-merta di berpuluh-puluh kawasan, termasuk persenyawaan in vitro.
- Alamat: Moscow, lorong Kolobovsky pertama, 4
- Waktu buka: Isnin-Jumaat. dari jam 8:00 hingga 21:00; Sabtu-Ahad dari 8:00 hingga 20:00
- Tapak: k31.ru
- Perundingan utama pakar: dari 6500 rubel.
- Program IVF: dari 54900 rubel.
- Inseminasi buatan: pengiraan individu
- Pada peta
Institusi perubatan telah dimasukkan dalam penarafan berkat kejayaan mengendalikan program IVF dan pelbagai perkhidmatan berkaitan. Ramai pesakit dengan bentuk ketidaksuburan yang teruk, serta ketidaksuburan yang berkaitan dengan usia, dibantu di sini. Punca ketidaksuburan cepat ditentukan, ujian makmal dijalankan sepanjang masa menggunakan peralatan terkini dari syarikat terkenal. Senarai tambahan termasuk ICSI, IMSI, PICSI, teks mengenai keserasian genetik pasangan, kualiti biomaterial. Ulasan bercakap secara positif mengenai pencegahan hiperstimulasi ovari yang berterusan. Dalam cryobank, biomaterial disimpan untuk sebarang tempoh atas permintaan pesakit. Ada program ibu tertangguh. Aduan khas tentang kualiti madu. Tiada perkhidmatan di klinik ini. Pesakit memuji doktor untuk IVF yang berjaya (sehingga 70%). Hanya di sini kos program yang kompleks kadang-kadang sangat sukar untuk dibeli.
- Senarai besar perkhidmatan yang berkaitan dengan program IVF
- Pengenalpastian cepat punca ketidaksuburan
- Analisis 24 jam di makmal
- Penyimpanan biomaterial yang tidak ditentukan dalam bank krio
- Harga tinggi
- Kadang-kadang anda perlu menunggu lama
Lihat juga:
5 teratas. Pusat Perubatan Pelbagai Bidang Klinik IVF Akademik Moscow (MAC IVF)
Pusat perubatan menyediakan diskaun, mengadakan promosi untuk pesakit dari semua bandar di negara ini.
- Alamat: Moscow, Bolshaya Pereyaslavskaya st., 46/2
- Waktu buka: setiap hari dari 8:00 hingga 20:00
- Tapak: mac-ivf.ru
- Perundingan utama pakar: dari 4500 rubel.
- Program IVF: dari 150,000 rubel.
- Inseminasi buatan: 40,000 rubel.
- Pada peta
Salah satu klinik IVF terbaik di Moscow. Pusat perubatan pelbagai disiplin ini mempunyai teknologi paling canggih: terdapat kedua-dua IVF di bawah insurans kesihatan wajib dan pada asas berbayar penuh. Berdasarkan ulasan, program di klinik agak berkesan. Ya, terdapat kesilapan, tetapi banyak bergantung bukan sahaja pada protokol yang dipilih, tetapi juga pada tubuh pesakit. By the way, di sini anda boleh mendapatkan latihan penuh untuk IVF untuk kedua-dua wanita dan lelaki. Pasukan pusat itu termasuk pakar andrologi berpengalaman, pakar obstetrik-ginekologi, pakar urologi, pakar reproduktif dan pakar genetik. Klinik ini juga memiliki bank penderma oosit dan spermanya sendiri.
- Dengan IVF di bawah insurans perubatan wajib, anda boleh menghantar dokumen dalam talian
- Penyelesaian yang berkesan untuk masalah kemandulan lelaki
- Temu janji awal dengan doktor dengan diskaun sehingga 40%
- Nasihat penginapan untuk orang luar bandar
- Doktor boleh menukar tanpa memberitahu pesakit
- Kadangkala pakar membuat kesilapan dalam proses peperiksaan.
Lihat juga:
4 teratas. ibu
Harga untuk temu janji awal dengan doktor di klinik ini adalah antara yang terendah dalam ranking.
- Alamat: Moscow, st. Raskovoy, 32
- Waktu buka: Isn.-Sab. 9:00-18:00
- laman web: ma-ma.ru
- Perundingan utama pakar: dari 2100 rubel.
- Program IVF: dari 166,750 rubel.
- Inseminasi buatan: 39796 rubel.
- Pada peta
Klinik ini telah berjaya beroperasi sejak tahun 1999. Pada masa ini, dia dua kali menjadi pemilik anugerah "Crystal Vial". Dan lebih daripada 12 ribu pesakit menjadi ibu bapa yang gembira. Berdasarkan penunjuk individu, doktor memilih rawatan yang paling berkesan untuk pesakit tertentu. Terdapat banyak ulasan positif mengenai institusi tersebut. Doktor menggunakan pencapaian terbaik dalam pembiakan antarabangsa bersama-sama dengan peralatan daripada pengeluar terkemuka. Di sini anda boleh melawat pelbagai pakar sempit: genetik, pakar reproduksi, andrologist, endocrinologist. Tetapi tidak semua doktor berkelakuan bijak semasa peperiksaan dan peperiksaan. Sesetengah pesakit tidak berpuas hati dengan sikap dingin, percubaan pakar untuk memerah wang sebanyak mungkin daripada pelanggan.
- Kaedah IVF yang paling berkesan digunakan
- Pendekatan individu terhadap rawatan
- Perundingan pakar berkaitan ada disediakan
- Harga optimum
- Kegagalan protokol berlaku
- Doktor lebih berminat untuk membayar daripada hasil rawatan
Lihat juga:
3 teratas. Sebelum
Kakitangan klinik mempunyai ijazah akademik, memiliki perkembangan berkesan dalam pembiakan dan bidang berkaitan.
- Alamat: Moscow, Potapovsky per., 4, bangunan 1
- Waktu buka: dari 9:00 hingga 20:00
- Tapak: priorclinic.ru
- Perundingan utama pakar: dari 3000 rubel.
- Program IVF: dari 160,000 rubel.
- Inseminasi buatan: 22,000 rubel.
- Pada peta
Sudah dari lawatan pertama ke klinik di pusat Moscow, pesakit berada di tangan pakar berpengalaman yang prihatin. Di sini mereka bekerja walaupun dengan kes kemandulan dan keguguran yang paling sukar. Institusi ini dilengkapi dengan peralatan peringkat pakar moden, di mana anda boleh menjalani peperiksaan yang diperlukan. Tiada apa-apa tambahan diberikan. Semua program IVF, termasuk insurans perubatan wajib, berfungsi, ujian genetik sedang dilakukan. Anda boleh menggunakan biomaterial penderma. Institusi ini mempunyai hospital sendiri. Apabila kehamilan berlaku, wanita diperhatikan oleh doktor mereka. Harga di klinik bukanlah yang paling demokratik, tetapi kualiti penjagaan adalah pada tahap. Benar, tidak semua pakar berhati-hati dan berhati-hati merawat pesakit mereka.
- Perkembangan penulis asal
- Memberi harapan apabila berhadapan dengan kes yang sukar
- Peralatan kelas pakar
- Pengurusan kehamilan
- Doktor acuh tak acuh dan biadap
- Kadang-kadang pakar mengenakan ujian mahal
Lihat juga:
2 teratas. Untuk kelahiran
Berbanding dengan pesaing dalam pasaran khusus, pusat perubatan menunjukkan satu daripada kadar tertinggi - 52.3% daripada keberkesanan program persenyawaan in vitro.
- Alamat: Moscow, Baumanskaya, 21
- Waktu buka: Isnin-Jumaat. dari 9:00 hingga 20:00; Sab. dari jam 10:00 hingga 18:00; Matahari. dari jam 10:00 hingga 16:00
- laman web: vrtcenter.ru
- Perundingan utama pakar: dari 3000 rubel.
- Program IVF: dari 168,000 rubel.
- Inseminasi buatan: dari 32,000 rubel.
- Pada peta
Klinik itu, sebagai tambahan kepada Moscow, juga mempunyai cawangan di Belgorod dan Yaroslavl. Keseluruhan kompleks persediaan prosedur boleh diselesaikan di tempat kediaman. Pusat perubatan ini terkenal bukan sahaja untuk keberkesanan program permanian yang dilaksanakan, tetapi juga untuk pelbagai perkhidmatan. Antaranya ialah ujian ERA, yang amat penting bagi mereka yang sudah mempunyai 2-3 protokol yang tidak berjaya dalam liabiliti mereka. Peserta penarafan mempunyai makmal genetiknya sendiri dan dibezakan oleh sekumpulan besar oosit dan sperma yang terpelihara. Ada program penderma, ibu tumpang. Pusat kesihatan reproduktif ini dianggap antara yang terbaik di ibu negara, tetapi ia mempunyai kelemahan yang ketara. Berdasarkan ulasan, doktor merawat pesakit dengan kuota dari negeri dengan dingin, kadang-kadang membuat kesilapan.
- Kecekapan tinggi program IVF
- Diskaun dan program bonus
- Ujian ERA ditawarkan
- Bank sendiri bagi oosit terpelihara, sperma
- Ia tidak selalu mungkin untuk pergi ke doktor pada masa yang ditetapkan dengan temu janji
- Sesetengah doktor tidak begitu cekap
Lihat juga:
1 teratas. REMEDI. Institut Perubatan Reproduktif
Kecekapan protokol IVF di klinik ini adalah antara yang terbaik, manakala kos pemeriksaan dan prosedur agak boleh diterima.
- Alamat: Moscow, Shmitovsky pr-d, 3s1
- Waktu buka: Isnin-Jumaat. dari 8:30 hingga 20:30; Sab. dari 9:00 hingga 18:00; Matahari. dari jam 10:00 hingga 16:00
- Tapak: remedicclinic.ru
- Perundingan utama pakar: melalui telefon
- Program IVF: dari 132,050 rubel.
- Inseminasi buatan: 35625 rubel.
- Pada peta
Sebuah klinik dengan pakar reproduktif yang berpengalaman, banyak pilihan program IVF dan cryostorage sendiri. Kos perkhidmatan di pusat perubatan adalah salah satu yang terbaik di Moscow. Berdasarkan ulasan, doktor bukan sahaja membantu untuk hamil, tetapi juga untuk melahirkan anak. Sokongan pesakit adalah yang terbaik di sini: anda boleh menghubungi doktor pada bila-bila masa sepanjang hari. Institut Perubatan Reproduktif menggunakan program yang berkesan - 44% pesakit di bawah umur 35 tahun menemui kebahagiaan keibuan buat kali pertama. Ngomong-ngomong, sebelum menghantar pasangan ke IVF, pakar pusat menjalankan pemeriksaan menyeluruh. Dan jika seorang lelaki dan seorang wanita mempunyai peluang untuk mempunyai bayi secara semula jadi dengan campur tangan yang minimum, maka doktor menetapkan rawatan dan membantu untuk menjadi ibu bapa tanpa IVF. Dalam kes yang teruk, kedua-dua rangsangan dan bahan penderma digunakan.
- Program pembekuan telur sendiri
- Diskaun 50% untuk konsultasi pertama dengan pakar obstetrik-ginekologi
- Doktor yang prihatin
- Membantu dalam kes yang sukar
- Doktor ultrasound yang kurang ajar terserempak
- Terdapat kesukaran dengan tempat letak kereta
Lihat juga:
Pusat Kesihatan Reproduktif "SM-Clinic"
Di SM-Clinic, pesakit menerima bantuan dari saat lawatan pertama mereka hingga bersalin. Doktor memantau perjalanan kehamilan, menjalankan pemeriksaan menggunakan peralatan moden.rn
- Alamat: Moscow, per. Raskovoy, d. 14/22
- Waktu buka: Isnin-Jumaat: 08:00-21:00, Sab-Ahad: 9:00-21:00
- laman web: sm-eko.ru telefon: 8 (495) 777 48 49 (pusat hubungan 24/7)
- Perundingan utama pakar: 2900 rubel.
- Program IVF: 90200-230700 rubel.
- Inseminasi buatan: dari 7600 rubel.
Pusat SM-Klinik untuk Kesihatan Reproduktif membantu keluarga menjadi ibu bapa yang bahagia. Makmal embriologi mempunyai inkubator berbilang gas, peralatan untuk manipulasi mikro dengan telur, penanaman embrio, dan pemilihan spermatozoa. Gabungan peralatan dengan kakitangan perubatan dari Persatuan Pembiakan dan Embriologi Eropah dan Persatuan Pembiakan Manusia Rusia memberikan kecekapan IVF sehingga 47%. Untuk makluman - nilai purata di kebanyakan klinik ialah 30-35%. Pusat ini menawarkan pesakit lima jenis IVF - klasik, dalam kitaran semula jadi, dengan rangsangan, dengan rangsangan berganda, dengan rangsangan dan cryoprotocol. Dalam kes yang sukar, ICSI, PICSI, penetasan digunakan. Klinik ini menawarkan program kelewatan ibu dan bapa - sperma dan telur yang sihat dibekukan untuk digunakan kemudian untuk persenyawaan. Doktor menjaga pesakit dari lawatan pertama hingga bersalin. Semasa kehamilan, kajian biokimia dijalankan, risiko keabnormalan kromosom pada ultrasound dengan perisian Astraia dikira, dan risiko hiperstimulasi diminimumkan. Pusat ini merawat ketidaksuburan wanita dan lelaki, melakukan pembedahan ginekologi dan urologi.Pesakit ditempatkan di hospital 24 jam mereka sendiri. Ulasan tentang klinik mendedahkan kelebihan tambahan - keramahan doktor dan kakitangan perubatan, sikap prihatin, tahap perkhidmatan yang tinggi.
- Kecekapan IVF sehingga 47%
- Pengurusan pesakit dari kemasukan ke penghantaran
- Makmal cryo sendiri
- Lima jenis IVF, kaedah tambahan
- Tak cukup parking sebelah klinik